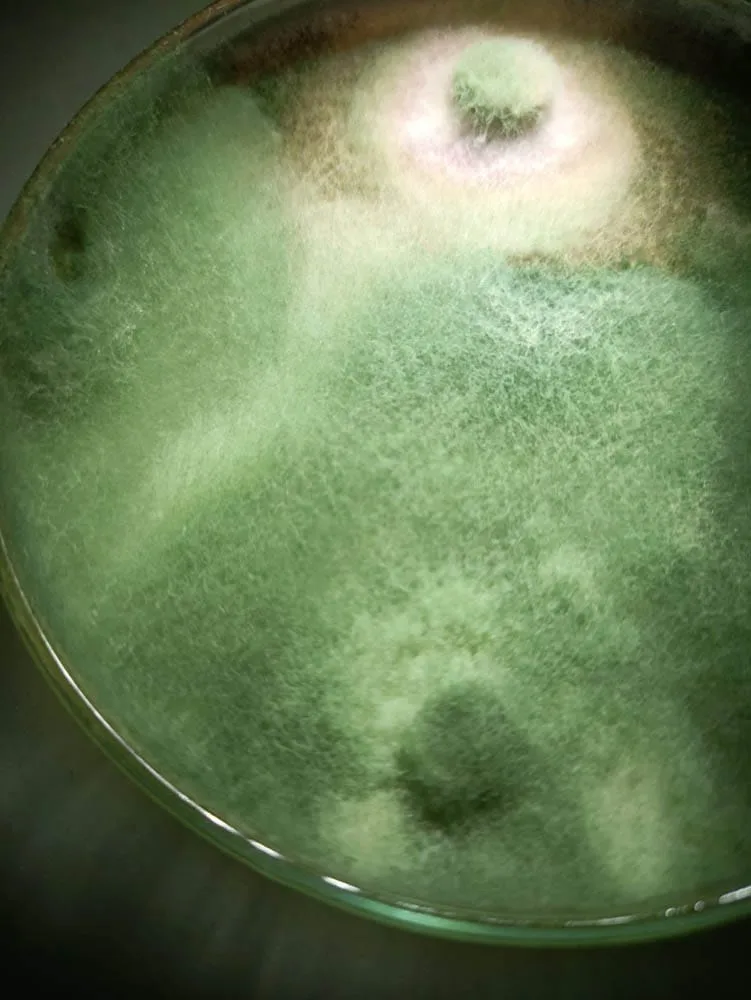
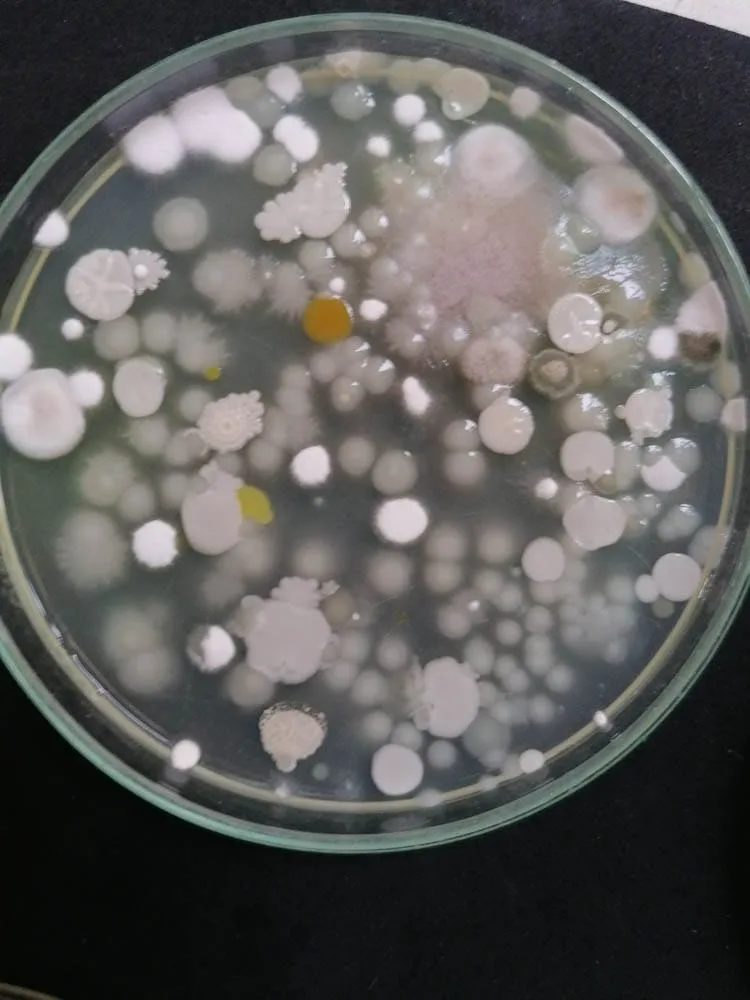

5 años de Experiencia
Bio Tecnología
Calidad
Acompañamiento
Soluciones Agropecuarias altamente efectivas
Bioandina Biotecnología es una empresa colombiana dedicada a la investigación y desarrollo de soluciones agropecurias mediante el uso de biotecnología aplicada.
Contamos con personal altamente calificado tanto en laboratorio como en campo que nos permite entender las necesidades de los productores y desarrollar programas eficientes para aumentar la productividad y rentabilidad de los cultivos.
El acompañamiento constante a agricultores y la observación en campo, nos ha permitido demostrar la efectividad de sistemas productivos alternativos mediante el uso de microorganismos con actividades enzimáticas diversas, que permiten la disminución del uso de pesticidas químicos y devolverle el equilibrio de la microfauna de los suelos.
NUESTROS SISTEMAS
GALERÍA DE IMÁGENES
Soluciones agropecuarias al servicio de sus cultivos
Póngase en contacto con
nosotros a través de los diferentes canales: